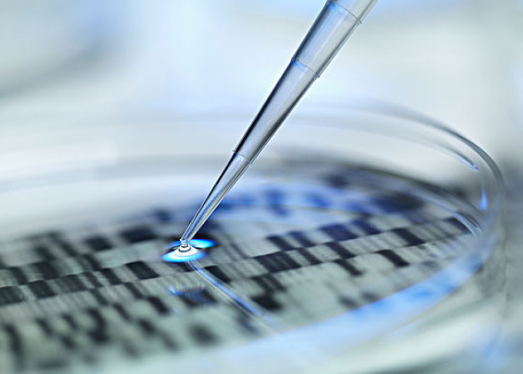
孕期無創DNA檢測多少錢 無創DNA檢測值得做嗎 孕期無創DNA檢測多少錢 無創DNA檢測值得做嗎

時間:2019-05-06 17:16:02來源:本站整理作者:fy點擊:
孕期無創DNA檢測是通過抽血的方式檢查胎兒的染色體異常,每個地區的檢測費用可能有所差距,有些家庭可能擔心無創dna檢測太貴了,那么孕期無創DNA檢測多少錢?值得做嗎?下面八寶網帶來介紹。

重慶無創DNA檢測降價到1400元/例!
讓惠于民,造福百姓!讓更多想做無創DNA檢測的孕媽媽,不再因為高昂的費用而糾結!
傳統唐氏篩查檢費用約200-400元。而無創DNA的成本比較昂貴,各地收費標準不同,一般在1000-3000元左右。
無創DNA的高價主要是由于相對先進的技術。目前可以做無創DNA的醫療機構相對有限,與唐篩相比,無創DNA具有無風險、無損傷、方便等多種優點。以上費用僅供參考,以檢測機構及時通知為準。然而,由于染色體異常事件的基本不能治愈。
一個有著染色體基因遺傳病的寶寶出生,帶來的是一個家庭的很重的經濟負擔以及這個寶寶也過的不快樂,所以有的時候可以選擇做一些檢查來防止這些不必要出現的問題。
什么是無創DNA檢測?
無創DNA是通過抽血的方式檢查胎兒染色體異常的方法。
無創DNA適合于孕期篩查21、18、13非整倍體異常,如檢測結果高風險,則有可能出現胎兒異?,F象,反之就算過關了。
另外,無創DNA對X和Y染色體異常檢測準確率也很高。
當無創檢查結果高危時,盡管準確率高,但我們還是要求做最終的產前診斷,即羊水穿刺和臍帶血穿刺。

無創DNA是利用基因測序技術進行產前篩查與診斷的一種方式,僅需采集孕婦外周靜脈血5毫升以上,提取出包含在母體外周血漿中的胎兒游離DNA片段,
通過新一代高通量DNA測序和生物信息分析,便可得知胎兒的遺傳信息,檢測出胎兒患染色體非整倍體疾病的風險率。
先了解下“染色體異?!?/p>
人類有46條23對染色體,包含了調控胎兒發育的全部遺傳信息。
如果多了一條或少了一條,都會造成胎兒嚴重的發育缺陷,甚至在妊娠的早期自動停止發育而自然流產。
多發的染色體病主要是21、18和13號染色體三體異常。
哪些人群需要做無創DNA檢查?
1. 高齡(年齡≥35歲)
2. 唐篩結果為高風險;
3. 孕期B超胎兒NT值增高或其它異常, ;
4. 有不明原因自然流產史、畸胎史、死胎或死產史的孕婦;
無創DNA檢查方式:
僅需采取孕婦靜脈血,檢測胎兒是否患21三體綜合征(唐氏綜合征)、18三體綜合征(愛德華氏綜合征)、13三體綜合征(帕陶氏綜合征)三大染色體疾病。
以上就是孕期無創DNA檢測多少錢,無創DNA檢測值得做嗎,請大家繼續關注。
網友跟帖
Copyright 2015-2020 8bb.com 〖八寶網〗 版權所有 鄂ICP備19016373號-1
聲明: 本站文章均來自互聯網,不代表本站觀點 如有異議 請與本站聯系 本站為非贏利性網站 不接受任何贊助和廣告
網友評論僅供其表達個人看法,并不表明八寶網立場。